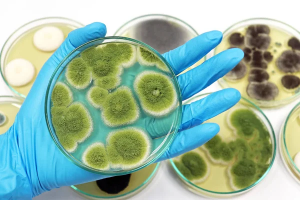
Giới hạn nấm men nấm mốc trong thực phẩm

Vệ sinh an toàn thực phẩm: 3 lầm tưởng về nấm men và nấm mốc
04:21 20/12/2025Nấm men và nấm mốc, chúng làm thực phẩm bị ôi thiu, gây ra quá trình lên men không mong muốn hoặc để lại mùi mốc
Giới hạn nấm men nấm mốc trong thực phẩm
04:17 04/05/2025Dưới đây là bài viết chi tiết về giới hạn nấm men nấm mốc trong thực phẩm, phù hợp để sử dụng trong tài liệu chuyên môn, truyền thông khoa học hoặc...
Các chỉ tiêu vi sinh vật trong thực phẩm
03:17 12/10/2024Các chỉ tiêu vi sinh vật trong thực phẩm là những yếu tố quan trọng giúp đánh giá mức độ an toàn và chất lượng vệ sinh của sản phẩm.